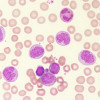

ALO, Dokter Hendra, izin bertanya dokter, adakah hubungan sebab akibat antara rutin donor darah dan kejadian polisitemia ya dok? Terima kasih
Donor darah rutin apakah dapat menyebabkan polisitemia - Penyakit Dalam Ask the Expert - Diskusi Dokter
general_alomedikaDiskusi Dokter
- Kembali ke komunitas
Donor darah rutin apakah dapat menyebabkan polisitemia - Penyakit Dalam Ask the Expert
Dibalas 08 Januari 2021, 13:02

dr. Reren Ramanda
Dokter Umum
ALO, Dokter Hendra, izin bertanya dokter, adakah hubungan sebab akibat antara rutin donor darah dan kejadian polisitemia ya dok? Terima kasih
Dibuat 08 Januari 2021, 12:48
08 Januari 2021, 12:57

dr. Hendra Gunawan SpPD-KKV
Dokter Spesialis Penyakit Dalam
Alo dokter,
Untuk saat ini kejadian polycythemia sekunder umum dijumpai pada keadaan hipoksemia kronis, seperti obstructive sleep apnea, PPOK.
Pada pasien polycythemia vera, mereka tidak dapat mendonorkan darahnya, namun instalasi darah dapat melakukan flebotomi terapeutik sebagai bagian dari manajemen polycythemianya dok.
Hingga saat ini, studi yang meneliti tentang hubungan tersebut melaporkan tidak ada hubungan antara donor darah dengan kejadian polycythemia vera:
https://pubmed.ncbi.nlm.nih.gov/26830533/